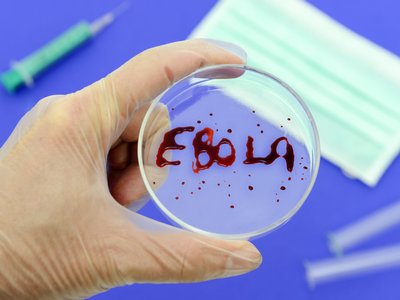

Вылечит ли Россия Африку от Эболы?
Заявление президента Владимира Путина о регистрации лекарства от лихорадки Эбола было быстро подхвачено на проходящем в Москве Гайдаровском форуме. Министр здравоохранения Вероника Скворцова в кулуарах сообщила о массовом производстве препарата и готовности поставлять его в страны Африки, где регистрируется это заболевание. Но сможет ли Россия вылечить от Эболы Африку, где уже в этом году ожидают новую вспышку этого заболевания?
 По словам Вероники Скворцовой, Россия «может выйти на большие партии – до 10 тысяч ампул в месяц». Средством заинтересовался Институт Пастера в Гвинее, традиционно занимающий сильные позиции в области тропической медицины. И российская фармацевтика готова удовлетворить его запросы, а также нужды стран Черного континента. «Мы будем готовы это сделать. Тем более что президент Владимир Путин вчера озвучил, что он уже дал такое задание министру иностранных дел – помочь нам в организации этой кампании», – сказала министр.
По словам Вероники Скворцовой, Россия «может выйти на большие партии – до 10 тысяч ампул в месяц». Средством заинтересовался Институт Пастера в Гвинее, традиционно занимающий сильные позиции в области тропической медицины. И российская фармацевтика готова удовлетворить его запросы, а также нужды стран Черного континента. «Мы будем готовы это сделать. Тем более что президент Владимир Путин вчера озвучил, что он уже дал такое задание министру иностранных дел – помочь нам в организации этой кампании», – сказала министр.
Как сообщила В.Скворцова, разработанная в России вакцина позволяет добиться «стопроцентной нейтрализации вируса». При этом он сохраняет свою эффективность и в очень низкой концентрации. Создан и другой препарат, позволяющий бороться с иммунодефицитом. Он тоже может быть важен для стран Африки с высоким уровнем инфицированности ВИЧ.
Заявления, прозвучавшие на Гайдаровском форуме, совпали с сообщением Всемирной организации здравоохранения о том, что эпидемия лихорадки Эбола, от которой умерли тысячи человек в странах Западной Африки, прекращена. «Всемирная организация здравоохранения объявляет об окончании последней по времени вспышки вирусной болезни Эбола в Либерии и сообщает, что все известные цепочки передачи остановлены», – цитирует ТАСС заявление ВОЗ, распространенное в Женеве.
Тем не менее «ожидаются новые всплески» болезни и в ближайшее время «исключительно важное значение» будет иметь наблюдение за эпидемиологической обстановкой.
По данным ВОЗ, в результате эпидемии лихорадки Эбола в Западной Африке погибли более 11 тысяч человек.
Большинство жертв пришлось на Гвинею, Сьерра-Леоне и Либерию, где существуют крупные популяции летучих мышей, летучих собак и прочих рукокрылых. Именно эти существа и считаются естественным резервуаром для вируса лихорадки Эбола. Местное население традиционно употребляет этих животных в пищу. Распространителями вируса также являются крупные человекообразные обезьяны – шимпанзе, гориллы, – а также домашние свиньи.
Наряду с этим распространению заболевания инфекции способствуют некоторые погребальные процедуры, при которых вирус передается от умерших. Поэтому ВОЗ вполне справедливо в этом году ожидает новой вспышки заболевания.
Эпидемии, вызванные вирусом Эбола, случались в этих странах и ранее, но все они быстро завершались естественным образом. В любом случае число умерших редко превышало сотню человек. Нынешняя волна заболевания, начавшаяся еще в 2014 году, стала наиболее опасной. Случаи заболевания регистрировались не только в странах Африки, но и в США, Великобритании, Испании.
До нынешней эпидемии лихорадка Эбола считалась редким заболеванием, поэтому крупные фармацевтические компании не были заинтересованы в проведении исследований.
Тем не менее с вирусом работали, о чем говорят случаи смерти сотрудников исследовательских лабораторий. Впервые вирусом Эбола заразился сотрудник одной из лабораторий в Великобритании, но ему удалось выжить. Позднее, в 1994 году удалось выжить лаборанту в Кот-д’Ивуаре, который также был инфицирован вирусом в ходе исследований.
В России было зарегистрировано два случая. Первый произошел в 1996 году в Сергиевом Посаде, где умерла лаборантка НИИ микробиологии Министерства обороны после того, как случайно уколола палец шприцем. А в 2004 году умерла сотрудница отдела особо опасных инфекций НИИ молекулярной биологии Государственного научного центра вирусологии и биотехнологии «Вектор» в поселке Кольцово Новосибирской области. Она тоже поранилась во время инъекций подопытным животным.
Анна Соколова,
ТПП-Информ
При перепечатке материалов ТПП-Информ ссылка на интернет-издание обязательна.
-
 27 января 2016 г.
Азат Фазлыев: «ТПП Башкортостана – главный лоббист интересов бизнеса не только в регионе, но и на мировой площадке»
27 января 2016 г.
Азат Фазлыев: «ТПП Башкортостана – главный лоббист интересов бизнеса не только в регионе, но и на мировой площадке»
-
 27 января 2016 г.
Туризм в России: от традиционного до экзотического
27 января 2016 г.
Туризм в России: от традиционного до экзотического
-
 26 января 2016 г.
Новый обвал рубля. Почему рубль еще может упасть ниже 80 за доллар?
26 января 2016 г.
Новый обвал рубля. Почему рубль еще может упасть ниже 80 за доллар?
-
 26 января 2016 г.
«Свиной» штамм проверяет Минздрав на прочность
26 января 2016 г.
«Свиной» штамм проверяет Минздрав на прочность
-
 26 января 2016 г.
Олег Сафонов: следует ожидать увеличения спроса на внутренний туризм
26 января 2016 г.
Олег Сафонов: следует ожидать увеличения спроса на внутренний туризм
-
 26 января 2016 г.
Александр Круглик: «Наш главный инвестор – покупатель!»
26 января 2016 г.
Александр Круглик: «Наш главный инвестор – покупатель!»




